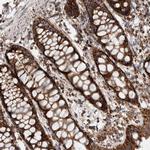
IARS2 Antibody in Immunohistochemistry (Paraffin) (IHC (P))

Search
Invitrogen
IARS2 Polyclonal Antibody
{{$productOrderCtrl.translations['antibody.pdp.commerceCard.promotion.promotions']}}
{{$productOrderCtrl.translations['antibody.pdp.commerceCard.promotion.viewpromo']}}
{{$productOrderCtrl.translations['antibody.pdp.commerceCard.promotion.promocode']}}: {{promo.promoCode}} {{promo.promoTitle}} {{promo.promoDescription}}. {{$productOrderCtrl.translations['antibody.pdp.commerceCard.promotion.learnmore']}}
产品信息
PA5-55117
种属反应
宿主/亚型
分类
类型
抗原
偶联物
形式
浓度
规格
纯化类型
保存液
内含物
保存条件
运输条件
RRID
产品详细信息
Immunogen sequence: VASQHNLPMD CLVDEDGVFT DVAGPELQNK AVLEEGTDVV IKMLQTAKNL LKEEKLVHSY PYDWRTKKPV VIRASKQWFI NITDIKTA
Highest antigen sequence identity to the following orthologs: Mouse - 83%, Rat - 81%.
靶标信息
The Trip230 gene encodes a protein of 1,978 amino acids with an estimated molecular mass of 230 kDa. The gene is located on chromosome 14q31, which is in a region associated with genetic alterations and thyroid hormone response abnormalities. The Trip230 protein interacts with Rb and thyroid hormone receptor (TR) using two distinct domains. Complex formation with Rb is in a hormone independent manner, but when Trip230 forms a complex with TR, it is in a thyroid hormone-dependent manner. After T3 treatment, Trip230 is phosphorylated and transported to the nucleus, suggesting that phosphorylation may be important for its nuclear translocation.
仅用于科研。不用于诊断过程。未经明确授权不得转售。
篇参考文献 (0)
生物信息学
蛋白别名: EC 6.1.1.5; IleRS; isoleucine tRNA ligase 2, mitochondrial; Isoleucine--tRNA ligase, mitochondrial; isoleucine-tRNA synthetase 2, mitochondrial; Isoleucyl-tRNA synthetase; isoleucyl-tRNA synthetase, mitochondrial; mitochondrial isoleucine tRNA synthetase; unnamed protein product
基因别名: CAGSSS; IARS2; ILERS
UniProt ID: (Human) Q9NSE4
Entrez Gene ID: (Human) 55699